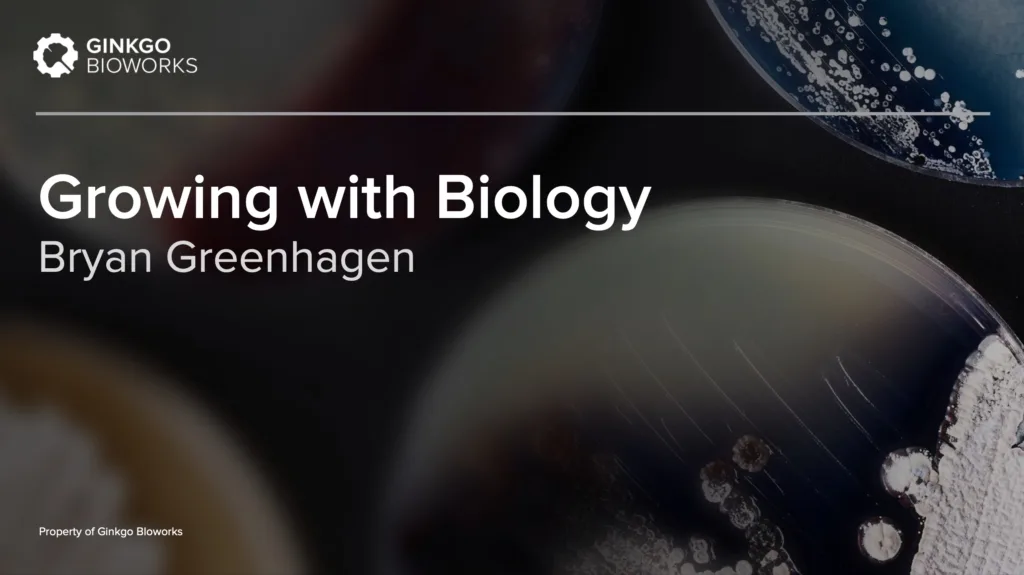
Ginkgo talk at ETSU

Thursday, October 27th, was a BIG BIO day in eastern Tennessee. That was when the “Growing the Future: Symposium on Innovation and Education for the Bioeconomy” was held at ETSU (East Tennessee State University), and it was a smashing success!

The symposium was organized and hosted by the ETSU Research Corporation. Its purpose: to showcase the momentum of the bioeconomy that’s “growing” in eastern Tennessee, as well as the untapped potential just waiting to be realized.
As David Golden, CEO of the ETSU Research Corporation, explains, “We have the educational platforms, partners, talent, facilities, and focus to drive bio-based innovation in the medical, industrial, and agricultural sectors.” Providing a gathering for the diverse stakeholders in this endeavor was a great way to promote the collaboration that will drive the bioeconomy in eastern Tennessee.
Here are some of the highlights
Session 1: Innovation and the Bioeconomy featured short talks from a trio of local leaders and slide presentations from two out-of-town guests representing Ginkgo Bioworks and the Department of Defense.

Session 2: Education and Workforce Development in the Bioeconomy brought no fewer than nine panelists to the mainstage. They represented a “supply chain” for the preparation of talent and the needs of industry in the region.


BioBuilder’s Dr. Natalie Kuldell was part of the Education and Workforce Development panel and brought her insights on how best to train the synthetic biology professionals of the near future. As she told WJHL Channel 11, the event was held to celebrate tomorrow’s possibilities in the region. “The possibilities for biology to do good in the world and be ready to solve the challenges of this next century, will happen here, can happen here.”
And that's not all!
More than 200 people attended the symposium, including community members, educators, and industry representatives.
Of course, BioBuilder teachers and Student Ambassadors were also there, bringing their enthusiasm and the promise of a bright future for the region’s residents and economy. As you can imagine, there was a lot to talk about!



Take aways...
It was clear that some of the regional stakeholders are already leading the way to a successful bioeconomy.
Tennessee Hills distillery and brewery (part of Rugged American Spirits) and ETSU have a distillation and fermentation training partnership that is creating a natural bridge to the bioeconomy. The fermentation and distillation program at ETSU will jumpstart future BioEngineering efforts at the University.


Northeast State Community College (NSCC) is a comprehensive, two-year community college. They provide career programs for students planning to enter the workforce immediately upon graduation and continuing education and community service programs.
Shown at left are Mary Tamer, President of BioBuilder’s Board of Directors, and Dr. Jeff McCord, President of NCSS, talking with a process engineering instructor inside one of their college’s classrooms.
The Niswonger Foundation creates opportunities for individual and community growth through education and sustainable projects. The Niswonger Foundation was established with the vision to make a positive and sustainable difference in education in Northeast Tennessee.

Ready, set, grow!

Photo, from left to right: Dr. Tom Tubon (BioMADE), Dr. Linda Latimer (ETSU Board of Trustees), David Golden (ETSU Reasearch Corp), Dr. Kate Sixt (Department of Defense), Dave Clark (ETSU Research Corp), Dr. Austin Che (Ginkgo Bioworks)
After the event, Dr. Tom Tubon — Chief Workforce Development Officer at BioMADE — said, “Thanks to so many for the opportunity to be a part of the conversation at the ETSU Growing the Future Bioeconomy Symposium. Under the leadership of those I had the fortune of meeting this week, the region is well poised for nothing less than prosperity and boundless success!”
Similarly, Law Loving from the Niswonger Foundation, wrote to say, “I thought the symposium was a smashing success and really laid out a strong vision for what our region could become. I know it inspired our team to think about our current efforts and future projects in a different light.”
Device Dude
On October 18th 2022, King Street Properties celebrated the groundbreaking of Allston Labworks in the Allston neighborhood of Boston. The mixed-use project will include 534,000 square feet of lab space to accommodate the modern life science industry and cutting-edge technologies.

A key highlight of the Allston Labworks development will be the Learning Lab – a science laboratory and classroom space hosting educational programs for regional students and our ever-growing life sciences industry. King Street has partnered with BioBuilder to run the Learning Lab.
“We are so proud to be breaking ground on this site,” said Mike DiMinico, Managing Director of King Street Properties. “Today marks the beginning of a true collaboration between development and community. Allston Labworks will not only bring new jobs to the local economy, provide needed housing, and support our vital life sciences sector, but will also provide ongoing engagement with students and neighbors, welcoming them to an industry that our team cares deeply about.”

Dr. Kuldell’s concluding remarks during the ceremony aptly express what this type of collaboration means for the BIO future:
“The last point I’ll make is that this week is MA STEM Week! How perfect, then, that we come together to open a space that might be this century’s version of the Public Library – a “Lab-rary” if you will – that welcomes all to successful careers, brighter futures, and a better world.”
